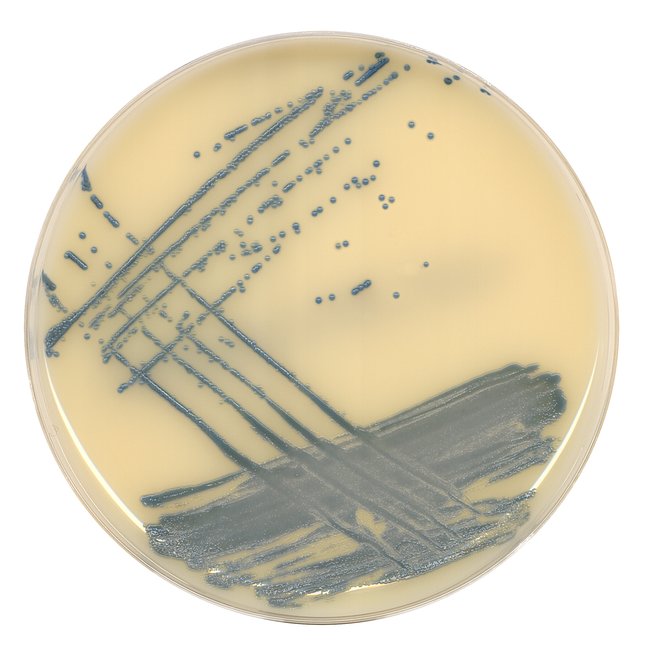

Spectra™ MRSA Medium, Pack of 10
$ 179.55
|
Details
Obtain fast and accurate results with a selective chromogenic medium for screening clinical samples for the presence of Methicillin Resistant Staphylococcus aureus.
Additional Information
SKU | 1137935 |
---|---|
UOM | Pack of 10 |
UNSPSC | 41116133 |
Manufacturer Part Number | R01821 |